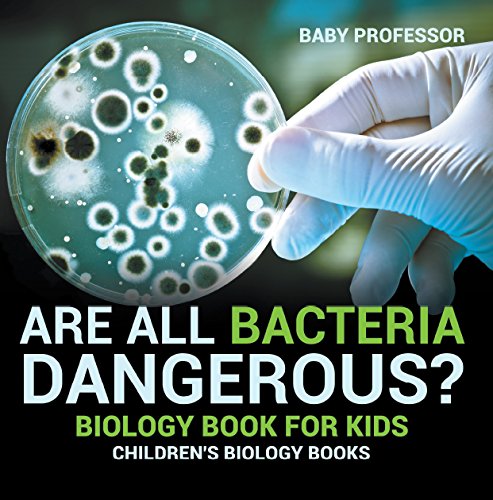
Are All Bacteria Dangerous? Biology Book for Kids | Children's Biology Books

10 Best Childrens Biology Books
#1 Best Pick

What Makes A Magnet?
Brand: HarperCollins Children's Books
Read more
- hands-on and visual
- acclaimed and trusted
- great for classrooms
- Entertain and educate at the same time
- Have appealing, child-centered topics.Developmentally appropriate for emerging readers.Focused; answering questions instead of using survey approach.Employ engaging picture book quality illustrations.Use simple charts and graphics to improve visual literacy skills.Feature hands-on activities to engage young scientists.Meet national science education standards.Written/illustrated by award-winning authors/illustrators & vetted by an expert in the field.
Check latest price on Amazon
#2 Best Value
Are All Bacteria Dangerous? Biology Book for Kids | Children's Biology Books
Brand: Baby Professor
Read more
Check latest price on Amazon
#3 Budget Pick

Oh Say Can You Say Di-no-saur?: All About Dinosaurs: Book 3
Brand: HARPERCOLLINSCHILDREN’SBOOKS
Read more
Check latest price on Amazon
#4 Top Choice

Biology for Queensland Units 1 & 2 Essential Access + Book: Queensland Certificate of Education (QCE)
Brand: Oxford University Press ANZ
Read more
Check latest price on Amazon
#5 Popular Choice

The Whole-Brain Child: 12 revolutionary strategies to Nurture Your Child's Developing Mind
Brand: Scribe Us
Read more
Check latest price on Amazon
#6 Top Pick

Hands Are Not for Hitting Board Book
Brand: Free Spirit Publishing
Read more
- Grades - PreK
- Weight - 0.72
- Depth - 7.00
- Width - 7.00
Check latest price on Amazon
#7 Top Pick

Childhood Disrupted: How Your Biography Becomes Your Biology, and How You Can Heal
Brand: Atria Books
Read more
- Childhood Disrupted How Your Biography Becomes Your Biology and How You Can Heal
Check latest price on Amazon
#8 Top Pick

Incredible But True: The Human Body - Kids Hardcover Book, Learn About Biology, STEM for Kids Aged 7-12, Color Illustrated Non-Fiction Books, Learning & Education
Brand: Incredible But True
Read more
- FULL OF FUN FACTS & EXPLANATIONS, the Incredible But True books are a fantastic and exciting resource for children.
- LEARN ABOUT all aspects of the fascinating and complex human body.
- ENCOURAGES CURIOSITY and introduces children to the wonders of biology.
- THE HUMAN BODY: Hours of exploring and information for kids ages 7-12.
Check latest price on Amazon
#9 Top Pick

The Senses of Smell and Taste Are Best Friends! - Biology 1st Grade | Children's Biology Books
Brand: Baby Professor
Read more
Check latest price on Amazon
#10 Top Pick

Life Cycles: Everything from Start to Finish
Brand: Penguin
Read more
- This product will be an excellent pick for you.
- It ensures you get the best usage for a longer period
- It ensures you get the best usage for a longer period
Check latest price on Amazon









